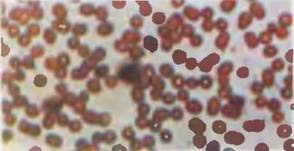

Запрет на клонирование Христа?

Легенда гласит, будто бы некая дама спросила у известного физика начала прошлого века, в чем ценность сделанного незадолго до того открытия. На что тот ответил вопросом на вопрос: а в чем ценность рожденного младенца? Никто не может знать, кто вырастет из мальчика, который «маленький с кудрявой головой»…
То же и с нашими клетками, которые поначалу способны превратиться во все, что угодно, то есть в любую клетку из более чем сотни тканей, составляющих наш организм. (Потенциал же клеток взрослого организма гораздо уже. Считается, что взрослые клетки могут дать лишь клетки своей ткани.)
Клетки с неограниченным потенциалом получили название стволовых.
И вокруг них в последнее время разгорелись нешуточные страсти.

Историческая справка
К своему удивлению, обнаружил в самой первой советской Медицинской энциклопедии, которую редактировал еще первый наркомздрав Се-1 машко, статью, посвященную Александру Александровичу Максимову (1874-1928). В статье указывается, что Максимов эмигрировал в 1922 году и провел свои последние годы в Чикаго, где активно занимался вопросами гистогенеза и воспаления.
Гистогенез – это образование наших тканей в ходе эмбрионального развития. Считается, что организм наш составлен тремя зародышевыми листками: снаружи экто-, изнутри эндо- и между ними мезодерма (от греч. «мезос» – середина, сравни: Месопотамия, или Междуречье).
Максимов работал в период бурного развития описательной медицины и биологии. Буквально накануне были переоткрыты законы Менделя, в 1908 году Нобелевскую премию дали нашему И.И. Мечникову, который постулировал центральную роль лимфоцитарного макрофага в таком важном защитном механизме, как воспаление, а через четыре года французу А. Каррелю, который разработал свой метод культуры тканей в той же Америке. С 1916 года метод взял на вооружение Максимов.
С его помошью он попытался разобраться под микроскопом в загадке, решение которой не далось Мечникову, а именно: откуда при воспалении появляется то множество клеток, накопление которых приводит к образованию флюса или нарыва?
Второй вопрос, который волновал его, это кроветворение. Известно, что клетки крови недолговечны. Максимальный срок их жизни не превышает двух месяцев. Так откуда же берутся новые? Понятно, когда клетки формируются в ходе развития зародыша, но во взрослом организме?

В результате своих скрупулезных исследований Максимов пришел к поразительному выводу.
Как написано в энциклопедии, он постулировал, что в нашем организме пожизненно сохраняются недифференцированные мезенхимальные, или камбиальные клетки, которые могут превращаться в лимфоциты и другие специализированные клетки соединительной ткани и крови.
Поясним, что термин «камбий» ученый позаимствовал из ботаники. Так называется тонкий слой клеток по периферии ствола дерева (стебля растения), который дает начало новым побегам-росткам. Часто можно видеть: дерево сломалось или спилили, а вокруг слома или пня уже растут новые веточки. Мезенхимой же эмбриологи называют «зародыш» будущей мезодермы, из которой образуется будущая соединительная ткань: кровь и кости, хрящи и сухожилия. Отметим, что клетки мезенхимы «выселяются» из нервной трубки, вот почему нейрон и лимфоцит генетические родственники. Да и функция у них сход-ная – различать вещества и воздействия.
Не удивительно, что в «простой, как правда» Америке Максимов вынужден был отказаться от заумной латыни и греческого и назвать увиденные им клетки стволовыми. Так этот научный сленг и закрепился в истории. О стволовых клетках писали как о «блуждающих клетках в покое, которые могут превращаться в различные клеточные формы». Тем самым он полагал, что решен спор о новообразовании клеток при воспалении.
Когда читаешь это сегодня, сразу же возникает вопрос: а что же наука делала долгие 80 лет! Что же она не пошла по широкому и ясному пути, указанному русским исследователем еще в середине 20-х? Все было в ее распоряжении: указание на существование «наследственных факторов», метод культуры и гипотеза стволовых клеток. Не забудем, что в самом начале тех же 20-х немец Ханс Шпеман сделал свои основные открытия в эмбриологии, за что в 1935 получил Нобелевскую. А Томас Морган, лауреат 1933 года, выпустил свою «Хромосомную наследственность» вообше в 1916 году.
Объяснений может быть два. Америка не была научным центром тогдашнего мира (вспомним «замолчанные» открытия П. Рауса, выделившего первый раковый вирус, получивший его имя, а также О. Эйвери, которому так и не дали Нобелевскую за доказательство генетической природы ДНК).
Каррель был уникумом, и это второе объяснение. Да, у него культуры каким-то чудом «переживали» десятки лет. но больше это до внедрения антибиотиков практически никому не удавалось. А потом люди больше были заинтересованы воспалением, которое возникает от множества причин, чем дифференцировкой.
Клетки крови (увеличено в 400 раз)
Тише мыши, клетки в нише
Дифференцировка – это процесс специализации клеток. Только в дифференцированном состоянии клетка может выполнять предназначенную ей функцию. Считается, что та же раковая клетка дедифференцирована, поэтому неудержимо делится, не подвергаясь апоптозу, то есть запрограммированной клеточной смерти.
Дифференцировка направляется экспрессией, то есть работой генов, в норме гены «молчат», но под воздействием различных внешних и внутренних факторов, например тех же гормонов, «включаются» и начинают свою экспрессию. Проявляющуюся в том, что синтезируются белки, закодированные в этих самых генах. Наиболее ярким примером всех этих процессов является вторичное половое созревание.
К началу 90-х в науке создались условия практического выделения стволовых клеток, о которых писал Максимов. Естественно, что первыми были выделены стволовые клетки костного мозга, который отвечает за кроветворение. Первая статья об изоляции гематопоэтических стволовых клеток человека появилась в журнале «Сайенс» 6 января 1995 года. Заметим, что гематомопоэз – это по-гречески кроветворение, а у мышей стволовые клетки крови начали выделять, начиная с 1991 года.
Двумя годами позже у тех же грызунов был обнаружен и нейрогенез во взрослом мозгу. До того все четко уяснили себе, что нервные клетки не восстанавливаются! И вдруг обнаружилось, что у крыс постоянно обновляются нейроны в отделе, заведующем обонянием. Выяснилось, что в глубине мозга крыс есть стволовые клетки, которые постоянно генерируют нейроны. Эти молодые нейроны «перебираются» в отдел, где клетки подвержены токсическому воздействию самых разных веществ, которые приходится нюхать подданным крысиного короля (навеяно воспоминаниями о «Щелкунчике»).
Для клетки мигрировать из глубины мозга в обонятельный отдел сравнимо с путешествием из Петербурга в Москву. Тем не менее потомки стволовых клеток постоянно совершают подобные перемещения в нашем мозгу. Что и слава Богу, поскольку это во многом спасает нас от дефицита нейронов в зрелом и пожилом возрасте.
В 1994 году в журнале «Нейчур» появилась статья о выделении самообновляющихся мультипотенциальных стволовых клеток и из коры головного мозга крысы, правда, эмбрионального.

Схема показывает жизненный путь стволовых клеток.
До поры до времени стволовые клетки покоятся в специальных нишах (вверху слева). Затем, подчиняясь внешнему сигналу, они начинают делиться, и часть их возвращается в дремлющее состояние (в центре вверху). Другая часть превращается в специализированные клетки (в центре внизу). Наконец, часть клеток-потомков мигрирует в иные области и там занимает пустые ниши, чтобы при необходимости пройти путь превращения в какой-либо вид специализированных клеток (справа).
Синим цветом показаны покоящиеся стволовые клетки красным – размножившееся их потомство, зеленым – зрелые специализированные клетки.
Тут необходимо сделать терминологическое пояснение. Эмбриональные стволовые клетки обладают неограниченным потенциалом в смысле генерирования дифференцированных «продуктов» самых разных тканей. Именно на этом их свойстве основан метод выключения генов: у одной из эмбриональных клеток выключают ген в хромосоме (клетка остается жизнеспособной из-за наличия нормального гена в другой хромосоме, вернее, хромосоме другого родителя). Со временем эта клетка, вернее, ее потомки попадают в половые железы, давая спермии и яйцеклетки. Соединение половых клеток с выключенными генами дает потомство без данного гена…
Из-за неограниченного потенциала стволовые клетки эмбриона называют плюрипотентными (вспомните столь модное не так давно слово «плюрализм»). А стволовые клетки взрослого организма нарекли мультипотентными – то есть со многими, но не всеми потенциями развития. Так оно и пошло, что перспективу видели именно в плюрипотентных ЭСК – эмбриональных стволовых клетках, клеткам же из взрослого организма отводилась вспомогательная роль.
Но тут препятствий масса вышла. Прежде всего, речь зашла об этике, в том числе и врачебной. Ведь ЭСК и по сей день берут от зародышей-эмбрионов, что для человека связывается с неприглядным словом «абортарий». Со всеми вытекающими отсюда медицинскими и социальными проблемами. Кроме того, ЭСК весьма капризны в плане жизнеспособности. Пример – сотни неудачных попыток при клонировании, что крайне удорожает сам этот процесс. Да к тому же ЭСК часто дают так называемые тератомы, или уродливые разрастания, что тоже никому не нужно.
Ну, а стволовые клетки взрослого организма? Тут существует проблема ре- или перепрограммирования. Ведь стволовая клетка из взрослой ткани уже прошла в своем развитии несколько стадий дифференцировки. Поэтому ее необходимо вернуть в «исходное» плюрипотентное состояние, хотя и считалось, что сделать это уже невозможно. Вот почему стволовые клетки взрослых дают «производные» в пределах своей ткани.

Двойная спираль молекулы ДНК
И тут выяснилось, что никакого перепрограммирования вообще нет, а есть образование тетраплоидных гибридов с эмбриональными стволовыми клетками (то есть имеющих не двойной, как положено нам от матери- природы, а четверной набор хромосом). А это не есть хорошо, поскольку мы знаем, что болезнь Дауна возникает уже при наличии всего лишь трех хромосом одной пары. Вполне возможно, что аномальные тетраплоиды вызывают и возникновение тератом – с этим еще предстоит разбираться.
Но вполне возможно, что «Нейчур» зазря бил тревогу. Сами же авторы статей о гибридах стволовых клеток указывали, что они образуются крайне редко. Для стволовых клеток эта величина составила олин гибрид на 10-100 тысяч культивированных клеток мозга. Но, тем не менее, проблема есть, и с нею еще предстоит разбираться. Однако выступление «Нейчура» может оказаться и актом драматизации для привлечения внимания ученых к стволовым клеткам вообще. Таким образом в свое время привлекали внимание к той ДН К-идентификации, без которой сейчас вроде бы и не обойтись…
Уже через какое-то время тот же «Нейчур» выдал на гора новый залп статей, результаты которых вселяют весьма оправданный оптимизм. Речь прежде всего зашла о нишах. Дело в том, что до сих пор выращивание стволовых клеток страдало эдаким «редукционизмом», то есть «вот стою я перед вами словно голенький». Но ведь в организме клетки всегда развиваются в клеточных нишах. Хотите пример – пожалуйста.
Нишей для развивающейся яйцеклетки является Граафов пузырек, или фолликул. В нем яйцеклетка-ооцит находится в состоянии «ареста», то есть приостановленного развития (сохраняя, кстати, парный набор хромосом). Блокирует жизненный цикл клетки, не давая ей дальше делиться, белок «циклин». за открытие которого была вручена Нобелевская премия по медицине и физиологии в юбилейном 2001 году.
В таких же нишах находятся и другие стволовые клетки взрослых тканей. Для тех же меланоцитов нашей шевелюры, придающих ей цвет, нишей, как выяснили сотрудники отдела молекулярной генетики Киотского университета, является дно волосяного фолликула. Убивание меланоцитов приводит к «поседению» мышек, а их стимуляция – к восстановлению окраски шкурки. Причем стимулированные стволовые клетки начинают мигрировать и заселяют освободившиеся ниши, превращаясь по пути в меланоциты.
Поясним в скобках, что меланоциты синтезируют красящее волосы вещество меланин из тирозина. Но из тирозина синтезируется и такой важный нейротрансмиттер, как допамин. При гибели нейронов, синтезирующих допамин, возникает тяжкое заболевание – паркинсонизм. Так что проблема стволовых клеток для меланоцитов и их ниш важна не только с косметологической точки зрения…
Подобные ниши обнаружены и в мозгу, в одной из них, кстати, образуются нейроны для обонятельной зоны, о чем шла речь выше. Теперь вот, как выяснили сотрудники Института медисследований Г. Хьюза в калифорнийском городе Ла-Джолла, такой же нишей является и гиппокамп. Это извилина «морского конька», напоминающая по своей завитой форме хвост удивительной рыбки, лежит в основании височной доли нашего мозга. То, что в гиппокампе генерируются нейроны и во взрослом состоянии, неудивительно, поскольку именно клетки этого отдела отвечают за память. А она ведь действует и развивается до глубокой старости…
Уже само по себе это открытие уникально, поскольку никто не предполагал наличия второй ниши нейрогенеза. Но вряд ли ради одного этого «Нейчур» чуть ли не через номер стал бы снова посвящать свои страницы стволовым клеткам (похоже, что журналу давно пора организовывать новое приложение типа «Нейчур-стволовой»).
Открытие, сделанное в Калифорнии, принципиального характера. Дело в том, что ранее полагали, что в мозгу есть нейроны – нервные клетки и поддерживающие их клетки глии, название которой происходит от греческого «глюон» – клей (так физики даже называют одну из своих элементарных «склеивающих» частиц). А тут оказалось, что астроглия – вид глиальных клеток, имеющих отростки, которые расходятся в разные стороны подобно лучам звезды, является главным компонентом той ниши, в которой нейробласты, то бишь стволовые клетки, превращаются в дифференцированные нервные клетки.
Стволовые нервные клетки уже давно пытались выращивать в присутствии различных глиальных клеток. И раньше считали, что глия – как и в M03iy, – «питает» нейроны. Но оказалось, что свойствами направления нейробластов на «путь истинный» обладает конкретная глия из гиппокампа, да к тому же постнатальная, то есть только после рождения мышонка. Именно эта астроглия ускоряет развитие нейронов в 8 раз! А вот глия из взрослого гиппокампа действует гораздо медленнее, а из спинного мозга не действует вовсе ни в каком возрасте.

Клетки коры головного мозга млекопитающего
Там впереди светлые дни
Не удивительно, что ученые прилагают все возможные усилия для того, чтобы хоть как-нибудь проследить судьбу стволовых клеток в культуре и не попутать одни с другими. Для этого в Ла-Джолле в нейробласты при помощи специальных методов ввели ген ЗФБ – зеленого флюоресцирующего белка, протеина медуз, благодаря которому обитатели тропических вод светятся в ночи. Астроциты же метились другим красителем и светились под микроскопом ярко-красным светом. Так что перепутать клетки разного происхождения было трудно.
А всего через пару месяцев появилась еще одна статья, на этот раз специалистов Национального института здравоохранения. Ученые описали методику «обогащения» нейропопуляций нейронов в среднем мозге, синтезирующих допамин. С помощью полученных допаминовых нейронов им удалось вылечить мышей с «моделью» паркинсонизма.
Формирование нейронов, синтезирующих допамин, осуществлялось довольно сложным путем, включающим пять стадий. Интересно, что на второй – довольно ранней стадии направленной дифференцировки, – клетки могли «уходить» в сторону инсулин-синтезирующих. Из-за гибели таких клеток и возникает сахарный диабет, «купируемый» инъекциями этого белкового гормона.
Очень важный шаг вперед был сделан исследователями из университета штата Миннесота в Миннеаполисе. Они сумели выделить из костного мозга взрослого организма плюрипотентные мезенхимальные стволовые клетки. При введении этих клеток в ранний бластоцист – бласт-«шарик», образованный эмбриональными клетками после шести-восьми делений зиготы, – из них образуются все известные клеточные типы. Новые клетки способны претерпевать более 80 делений без признаков старения или потери потенциала к дифференцировке! Причем все это сделано на клетках человека.
Есть в английском такое хорошее выражение «Ноу пэйн ноу гэйн» (дословно: нет боли – нет обретения, что-то вроде нашего «любишь кататься…»). Так вот, комментируя перспективы, которые открываются в связи с открытием нового типа стволовых клеток взрослого костного мозга человека, журнал пообещал всяческие медицинские гэйны без этических пэйнов, или весьма ощутимый навар без всякой головной боли с чиновниками и всякого рода активистами «Права на жизнь».
Это практика, но есть и теория. В настоящее время большой проблемой является так называемый импринтинг, или «замалчивание» генов. Почему-то замалчиваются многие гены в яйцеклетке и весьма малое их количество в спермии. Вполне возможно, что это связано с тем, чтобы предупредить – по крайней мере, у млекопитающих и птиц – самопроизвольное развитие яйцеклеток (партеногенез). То есть на молекулярном уровне существует запрет на клонирование Христа. А недавно все журналы взорвались сериями статей, посвященных описанию замалчивания генов как нового механизма возникновения рака.
И два слова о деньгах, которые науке приходится зарабатывать самой. Паркинсоники и жертвы болезни Альцгеймера – это пожилые люди, которые в рабочем возрасте не зарабатывали столько, чтобы теперь оплатить свое лечение с помощью «выведенных» в культуре стволовых клеток. Но помните, что при получении допаминэргических нейронов стволовые клетки на второй стадии воздействия вдруг начинали синтезировать инсулин. А инсулин-купируемым диабетом заболевают в детстве, юношестве и молодом самом активном возрасте.
За детей и юных отроков сейчас способны заплатить их родители, молодые же бизнесмены и вумены способны заплатить и сами. А только в США насчитывается до 10 миллионов диабетиков, пусть и разных (миллион уж точно зависим от инсулина). И это миллиарды долларов, которые способны заработать биотехнологические фирмы, чьи акции учитываются индексом НАСДАК.

Схема действия стволовых клеток в луковице волоса. Слева направо: стволовые клетки (5С) начинают действовать и, размножаясь (АС), создают нормальную волосяную луковицу, состоящую из зрелых клеток (МС). Из нее вырастает нормальный волос.
В свое время мало кто бы дал денег Амперу, Эрстеду и Фарадею. У последнего был свой лорд, «подвинутый» на электричестве, как Ломоносов и Риман. Лорд даже сжег как-то алмаз стоимостью две тысячи тогдашних фунтов, чтобы доказать силу вольтовой дуги. Гете жаловался, что все свои знания он добыл, истратив фамильное состояние, доставшееся ему от отца. Деньги же в электротехнику потекли только в конце XIX века, когда стало возможно строить первые электростанции.
То же и с биотехнологией, в которую инвестиции потекли в связи с налаживанием в США производства пенициллина. Только после масс-продукции этого биотехнологического товара, избавившего армию союзников от страха перед сифилисом, появился избыточный капитал, который стали направлять на развитие. Сегодня мир держится на биотехнологическом инсулине и интерфероне, а также ген-модифицированных сельскохозяйственных культурах и породах скота.
Но у людей биотехнологические продукты пока больше диагностируют, чем лечат. А так хочется вновь обрести молодую печень и почки, а также избавиться от сердечных приступов и провалов в памяти. Ученые надеются, что с помощью стволовых клеток им удастся…
Более 800 000 книг и аудиокниг! 📚
Получи 2 месяца Литрес Подписки в подарок и наслаждайся неограниченным чтением
ПОЛУЧИТЬ ПОДАРОК